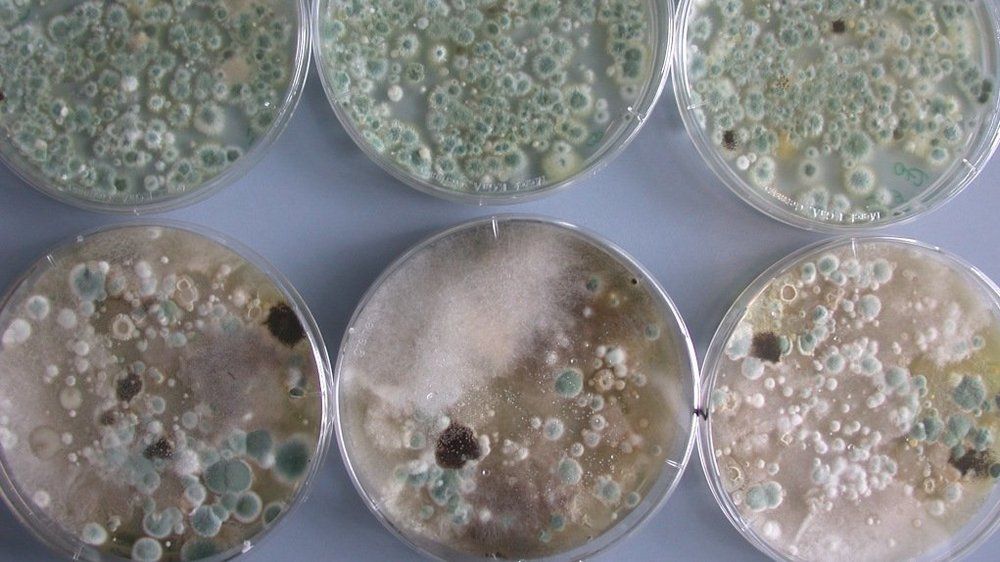
Agrarplatten zum kulturbasierten Nachweis von Mikroorganismen

Bioaerosole - Mikrobielle Luftverunreinigungen
Agrarplatten zum kulturbasierten Nachweis von Mikroorganismen
Unter Bioaerosolen versteht man alle luftgetragenen Partikel biologischer Herkunft. Umweltmedizinisch relevant können Bakterien, Pilze, Viren und Pollen sein. Da Mikroorganismen an der Zersetzung organischen Materials in der Umwelt beteilig sind, sind sie natürlicher Bestandteil in der Außenluft. Allerdings treten auch in allen Arbeitsbereichen, bei denen mit organischem Material umgegangen wird, Emissionen von Bioaerosolen auf. Deshalb sind alle Entsorgungsanlagen oder auch landwirtschaftlichen Betriebe potentielle Bioaerosolemittenten. Dazu zählen bspw. Kompostierungs- und Vergärungsanlagen, eine Vielzahl weiterer Anlagentypen zur Sortierung, Behandlung und Aufbereitung von Wertstoffen, wie z. B. Altpapier-, Gewerbeabfall- und Wertstoffsortieranlagen sowie Anlagen zum Halten oder zur Aufzucht von z. B. Mastgeflügel, Hennen, Schweinen oder Rindern.
Bioaerosole aus Anlagen können je nach Anlagentyp über mehrere hundert Meter nachweisbar sein. Um diesen Anlageneinfluss in der Umgebung erfassen und bewerten zu können, werden Leitparameter (wie z. B. Penicillium ssp. oder Aspergillus ssp. für Gewerbeabfallsortieranlagen) oder anlagenspezifische Messparameter bestimmt, deren Konzentration üblicherweise in der natürlichen Hintergrundbelastung jahreszeitlich wenig variiert oder nicht nachweisbar ist. Zur Probenahme erfolgt die Abscheidung in der Luft über das sogenannte Impingementverfahren, also die Abscheidung von Partikeln in Flüssigkeiten. Daran anschließend erfolgt der Nachweis durch den Aufwuchs auf Nährmedien und das Auszählen der koloniebildenden Einheiten (KBE).
Die Exposition gegenüber Bioaerosolen im Außenbereich wird seit Jahren als relevantes umweltmedizinisches Problem gesehen, weil Bioaerosole sehr unterschiedliche humanpathogene Wirkungen haben können. So können sie nach inhalativer Aufnahme die Gesundheit des Menschen durch infektiöse, allergische oder toxische Wirkmechanismen beeinflussen. Der Rat von Sachverständigen für Umweltfragen hat das Thema bereits im Umweltgutachten 2004 aufgegriffen, auf die möglichen Gesundheitsrisiken hingewiesen und eine wirksame Reduzierung der Bioaerosolemissionen gefordert.
Die gesetzlichen Vorgaben zur Begrenzung mikrobieller Emissionen basieren auf § 5 (1) BImSchG und sind in Nr. 5.2.9 der TA Luft konkretisiert. Darüber hinaus bestehen für den Arbeitsschutz technische Regeln, die sich mit der Einwirkung von Bioaerosolen auf den Menschen befassen (z. B. Technische Regeln für biologische Arbeitsstoffe (TRBA)). Der ‚Leitfaden zur Ermittlung und Bewertung von Bioaerosol-Immissionen der Bund/Länderarbeitsgemeinschaft für Immissionsschutz‘ vom 31.01.2014 unterstützt bei der Frage, ob eine Sonderfallprüfung nach Nr. 4.8 TA Luft erforderlich, und ggf. eine entsprechende Einzelfallprüfung durchzuführen ist. Beispielhafte Hinweise, für die Notwendigkeit einer Prüfung auf Bioaerosolbelastungen sind:
- geringer Abstand zwischen Wohnort/Aufenthaltsort und Anlage
- ungünstige Ausbreitungsbedingungen, z. B. Kaltluftabflüsse in Richtung der Wohnbebauung
- weitere Bioaerosol emittierende Anlagen in der Nähe
- empfindliche Nutzungen (z. B. Krankenhäuser)
- gehäufte Beschwerden der Anwohner über gesundheitliche Beeinträchtigungen.
Die Richtlinienreihe
- VDI 4250 umweltmedizinische Bewertung von Bioaerosolen und biologische Agenzien
- VDI 4251 Erfassen luftgetragener Mikroorganismen und Viren in der Außenluft
- VDI 4252 Erfassen luftgetragener Mikroorganismen und Viren in der Außenluft
- VDI 4253 Bioaerosole und biologische Agenzien – Kultivierung
- VDI 4255 Bioaerosole und biologische Agenzien - Emissionsquellen und –minderungsmaßnahmen
- VDI 4257 Messen von Bioaerosol-Emissionen
bietet die Grundlage für die Messung und Beurteilung von Bioaerosol-Immissionen.
Gesetz zum Schutz vor schädlichen Umwelteinwirkungen durch Luftverunreinigungen, Geräusche, Erschütterungen und ähnliche Vorgänge (Bundes-Immissionsschutzgesetz – BImSchG), in der Fassung der Bekanntmachung vom 17. Mai 2013 (BGBl. I S. 1274; 2021 I S. 123), das zuletzt durch Artikel 1 des Gesetzes vom 24. September 2021 (BGBl. I S. 4458) geändert worden ist
Erste Allgemeine Verwaltungsvorschrift zum Bundes–Immissionsschutzgesetz (Technische Anleitung zur Reinhaltung der Luft – TA Luft), GMBl Nr. 48-54/2021
Übersicht der aktuellen VDI-Richtlinien zu Bioaerosolen
Fachbeiträge
Kummer, Philipp: Bioaerosole- Maßnahmen zur Reduzierung der Bioaerosolemissionen in der Abfallwirtschaft, Müllhandbuch KZ 5066 2004
UBA/BMBF-Fachgespräch „Mikroorganismen in der Umgebung von Bioabfallbehandlungsanlagen“ vom 30.09.2004 in Bonn
Kummer, Büchen: Bioaerosolemissionen und Standortwahl, VDI- Berichte Nr. 1777, 2003
Kummer, Haumacher, Philipp, Böhm: Untersuchungen zum Abscheideverhalten von Abluftreinigungsanlagen im Hinblick auf Bioaerosole Gefahrstoffe - Reinhaltung der Luft, Bd. 63, S. 368 -372 2003
Kummer: Bioaerosolemissionen bei der biologischen Abfallbehandlung und mögliche Minderungsmaßnahmen; Schriftenreihe WAR 150 TU Darmstadt, S. 101-114 2003
Kummer, Kühner, Hausmann: Emissionsquellen und -minderungsmaßnahmen von Bioaerosolen bei der Kompostierung; Gefahrstoffe - Reinhaltung der Luft, Bd. 61, S. 239 - 244 2001
Kummer: Bioaerosole im Umfeld von Kompostierungsanlagen - Erfahrungen aus dem Vollzug; 7. Münsteraner Abfallwirtschaftstage, S. 167 - 172, FH Münster 2001
Kummer et al.: Mikrobielle Luftverunreinigungen: Emissionsquellen und -minderungsmaßnahmen; Gefahrstoffe - Reinhaltung der Luft, Bd. 59, S. 241 - 246 1999
Göttlich, Beck, Böhm, Danneberg, Gerbl-Rieger, Hofmann, Koch, Kühner, Kummer, Liebl, Martens, Missel, Neef, Palmgren, Rabe, Schilling, Tilkes, Wieser: Erfassung von luftgetragenen kultivierbaren Mikroorganismen aus Kompostieranlagen - Emission und Immission; Gefahrstoffe - Reinhaltung der Luft, Bd. 59, S. 209 - 218 1999
Kummer: Sind Keimemissionen im Umfeld von Kompostierungsanlagen tatsächlich ein Problem?; 6. Münsteraner Abfallwirtschaftstage, S. 193 - 196, FH Münster 1999
Schriftenreihe HLfU/HLUG
Mikroorganismen in der Umgebung von Abfallbehandlungsanlagen, 2003
Umweltmedizinische Relevanz von Emissionen aus Kompostanlagen für die Anwohner HMULF 1999
Leitlinien für den Arbeitsschutz in biologischen Abfallbehandlungsanlagen HSL
Keimimmissionen im Umfeld von Kompostierungsanlagen - Heft 232, 1995



